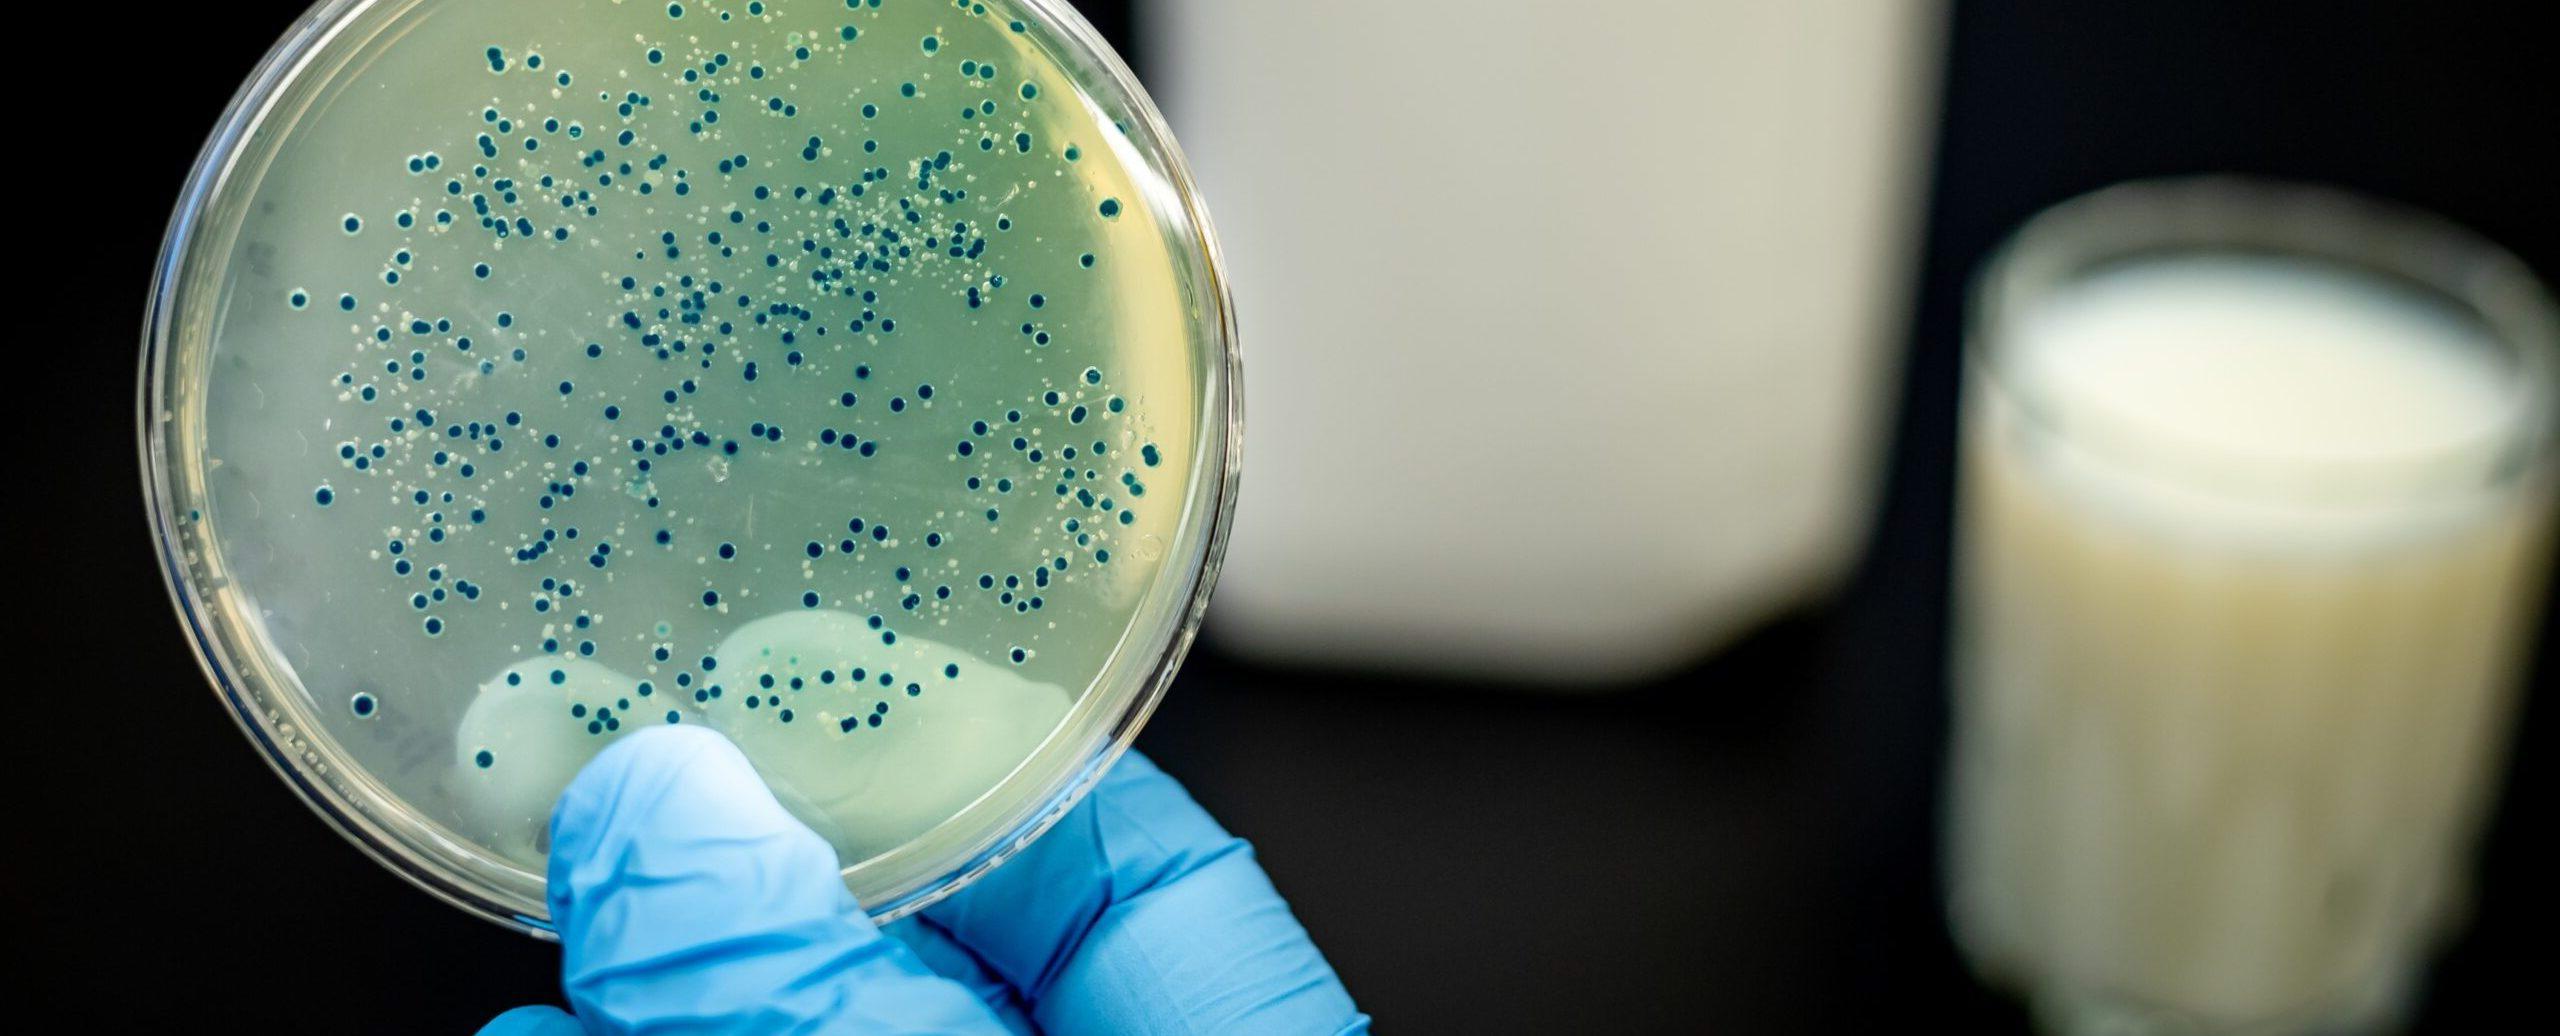
Hauschke + Leusder GmbH, Beisenbusch 9-11 in Nottuln

Hauschke + Leusder GmbH
in Nottuln
Labor
Adresse
Beisenbusch 9-1148301 Nottuln Zur Webseite
Kontakt
Telefonnummer: 025099953191
E-Mail: info@labor-hl.de
Öffnungszeiten
Mo. 09:00 - 16:00Di. 09:00 - 16:00
Mi. 09:00 - 16:00
Do. 09:00 - 16:00
Fr. 09:00 - 16:00
Sa. Geschlossen
So. Geschlossen

Gesundheit
Gesundheit Medizin
Medizin